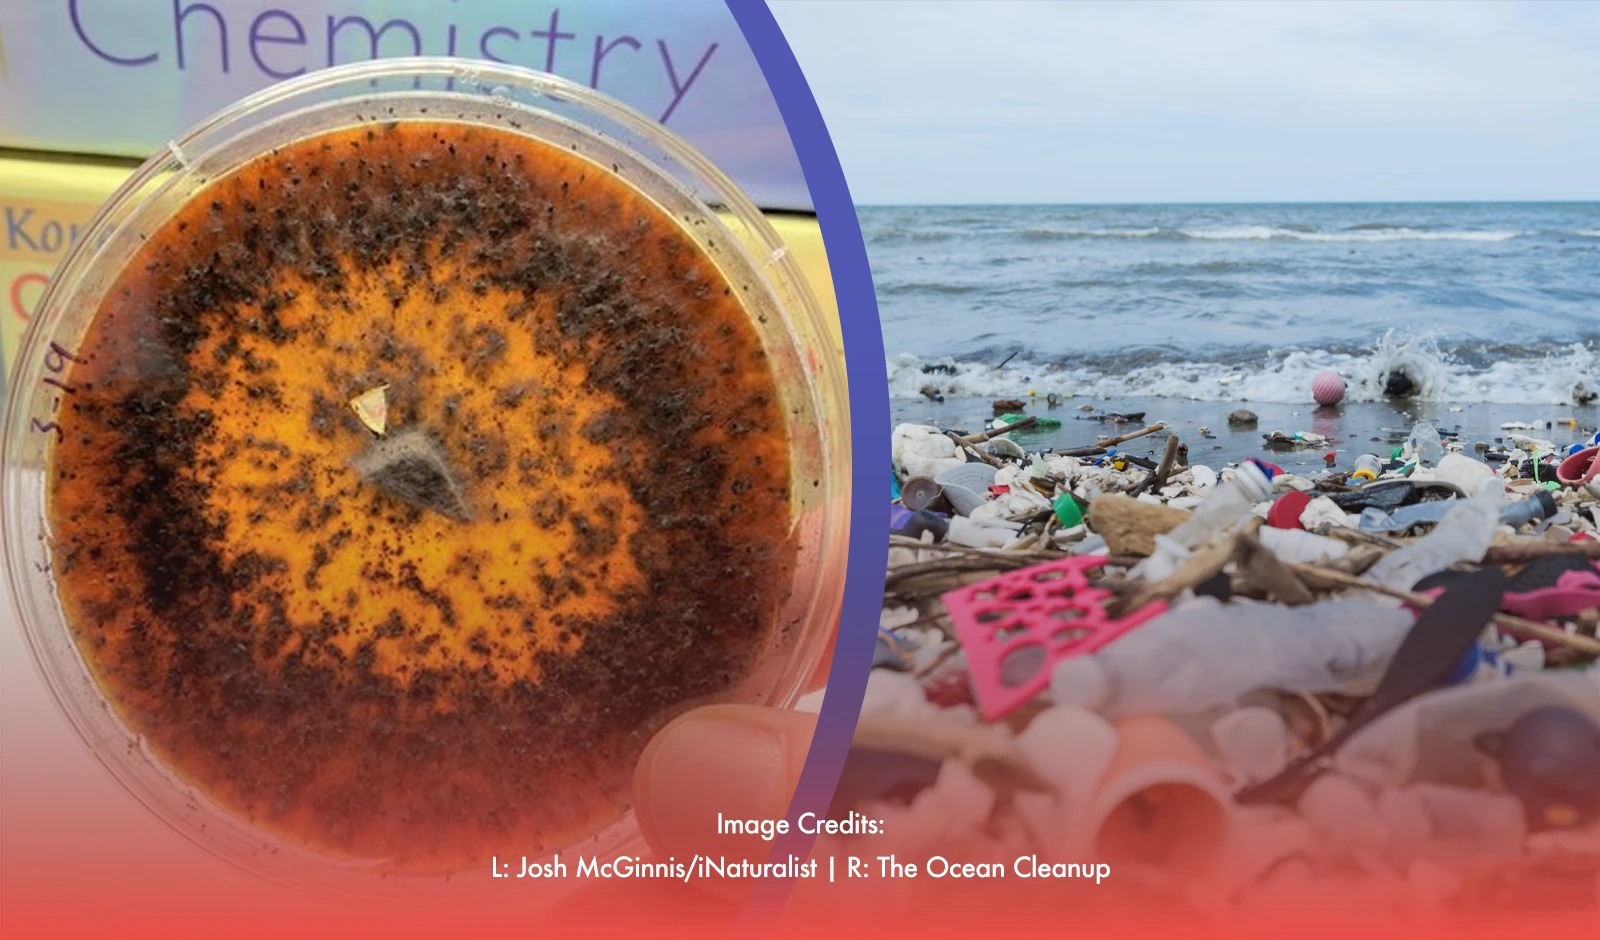
Plastic-Eating Fungi Provide Hope In World's Ocean Pollution Dilemma

German scientists have discovered fungi that consume plastic, which may provide some hope in addressing the issue of millions of tons of rubbish that end up in the world's oceans each year.
The lengthy polymer chains that comprise plastics can be broken down by these fungi, resulting in simpler molecules. Compared to the hundreds of years it can take for plastic to disintegrate, they can accomplish the decomposition process rather fast.
Plastic-eating fungi
One of these fungi, dubbed Aspergillus tubingensis, was found in a Pakistani trash. Researchers discovered that it might degrade the plastic polyester polyurethane in a few short weeks.
In the Amazon rainforest, Pestalotiopsis microspora, another type of fungus, was also discovered. This species presents a potential remedy for plastic waste in wetlands and oceans since it can digest plastic even in moist conditions and thrives in oxygen-free settings.
Because plastics are inexpensive, strong, and utilized in a wide range of items, their environmental buildup has gotten out of control. Nonetheless, there is hope that the discovery of fungi that consume plastic may greatly lessen the issue of plastic.
Promising resort against pollution
According to figures from the Plastics Europe Plastics Producer Association, global plastic production increased from 1.7 million tonnes in 1950 to almost 390 million tonnes in 2021. Less than 10% of plastic garbage is recycled globally, despite recent increases in the recycling rate.
The identification of fungi that consume plastic is encouraging, but further study is required before this approach can be widely used.
To make sure these fungi can effectively decompose various kinds of plastics, scientists are looking for ways to harness their power in controlled settings. Furthermore, scientists are trying to accelerate the rate of plastic breakdown in order to make it a practical way to handle the billions of tons of plastic trash generated annually.